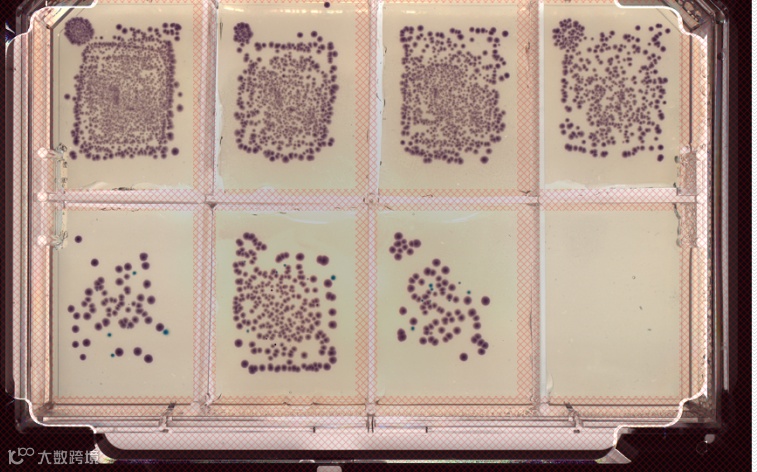
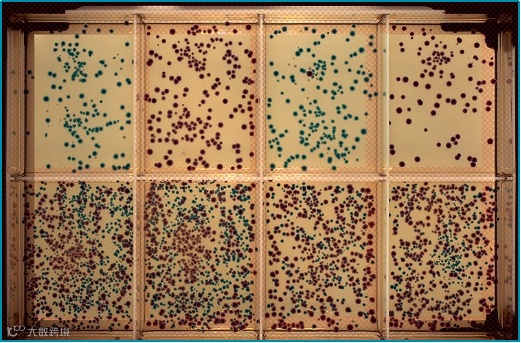
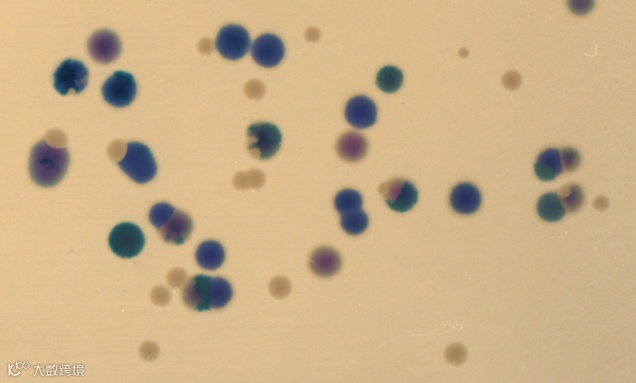

Molecular Devices 隆重推出微生物克隆筛选系统全新成员—— QPix FLEX 微生物克隆筛选系统。这是一款可以替代手工标准化挑菌、工作流程兼容度高、使用成本低,又可以轻松放置在厌氧培养箱中的创新产品。



亮点一

亮点二

亮点三

亮点四
让我们来一起揭开新品神秘面纱

此次新品发布,标志着 QPix 微生物筛选系列产品又向更高端迈进了一步,可以更好地满足不同客户灵活的应用需求。QPix Flex 的创新性功能,帮助更多研究人员解放人力,助力合成生物学、酶进化、菌种改造、菌落分离等应用方向获得全新见解。
新品更多性能,欢迎关注 Molecular Devices 公众号及 QPix FLEX 新品发布会公告。



若您有采购意向或申请样机试用
欢迎扫码填写表单留下您的信息
期待与您进一步沟通!
★
★



关于美谷分子仪器
Molecular Devices 始创于上世纪 80 年代美国硅谷,并在全球设有多个代表处和子公司。2005 年,Molecular Devices 在上海设立了中国代表处,2010 年加入全球科学与技术的创新者丹纳赫集团,2011 年正式成立商务公司:美谷分子仪器 (上海) 有限公司。Molecular Devices 以持续创新、快速高效、高性能的产品及完善的售后服务著称业内,我们一直致力于为客户提供在生命科学研究、制药及生物治疗开发等领域蛋白和细胞生物学的创新性生物分析解决方案。